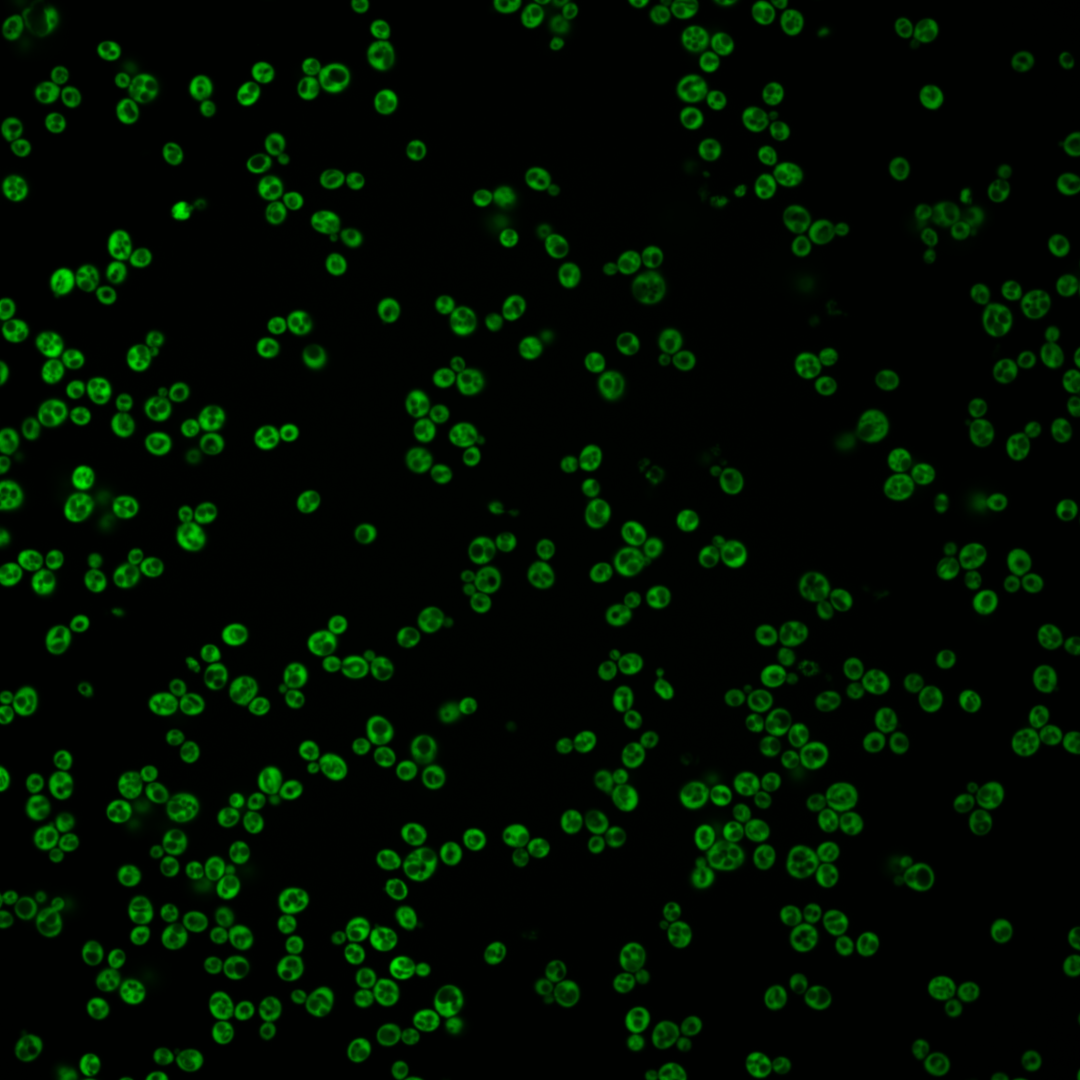
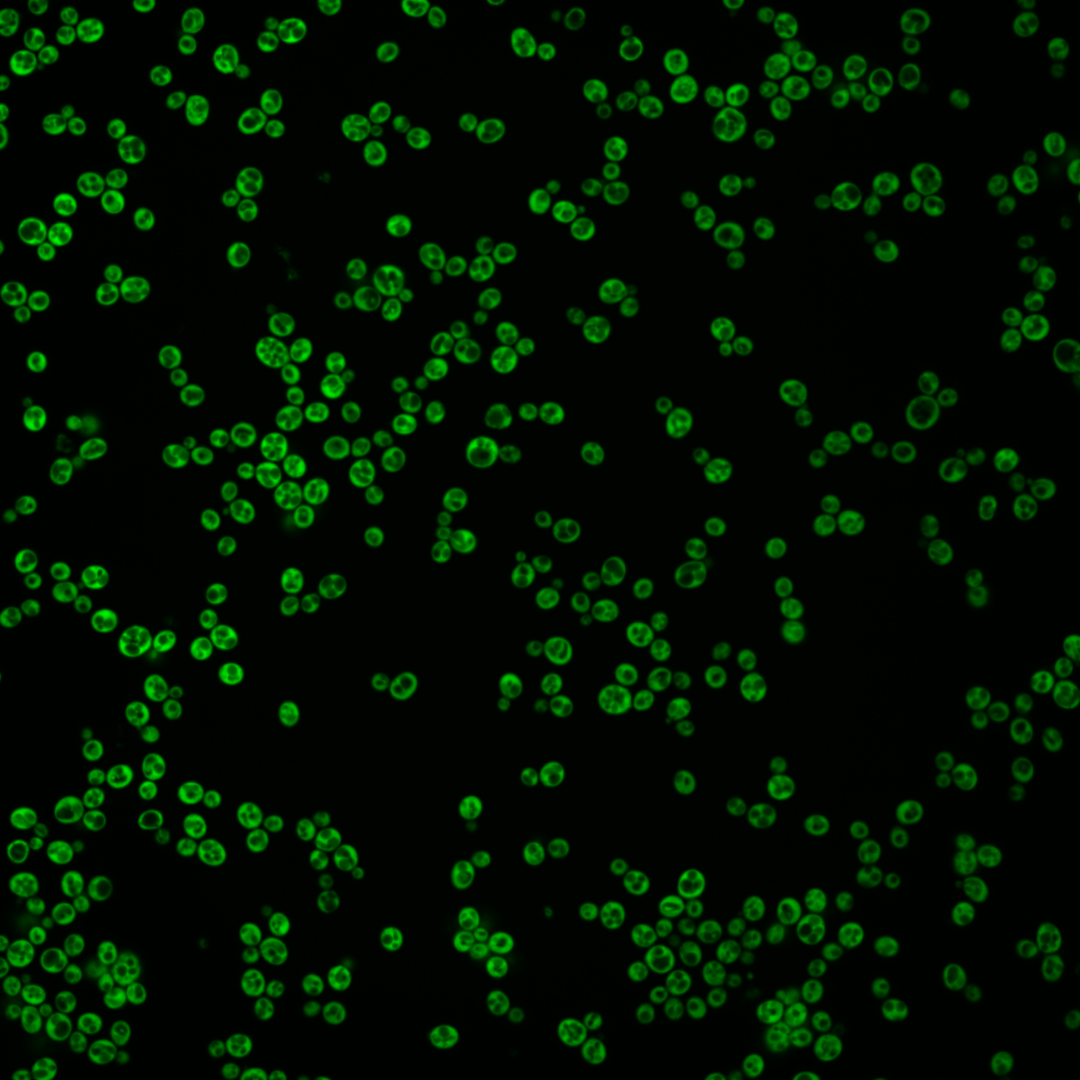
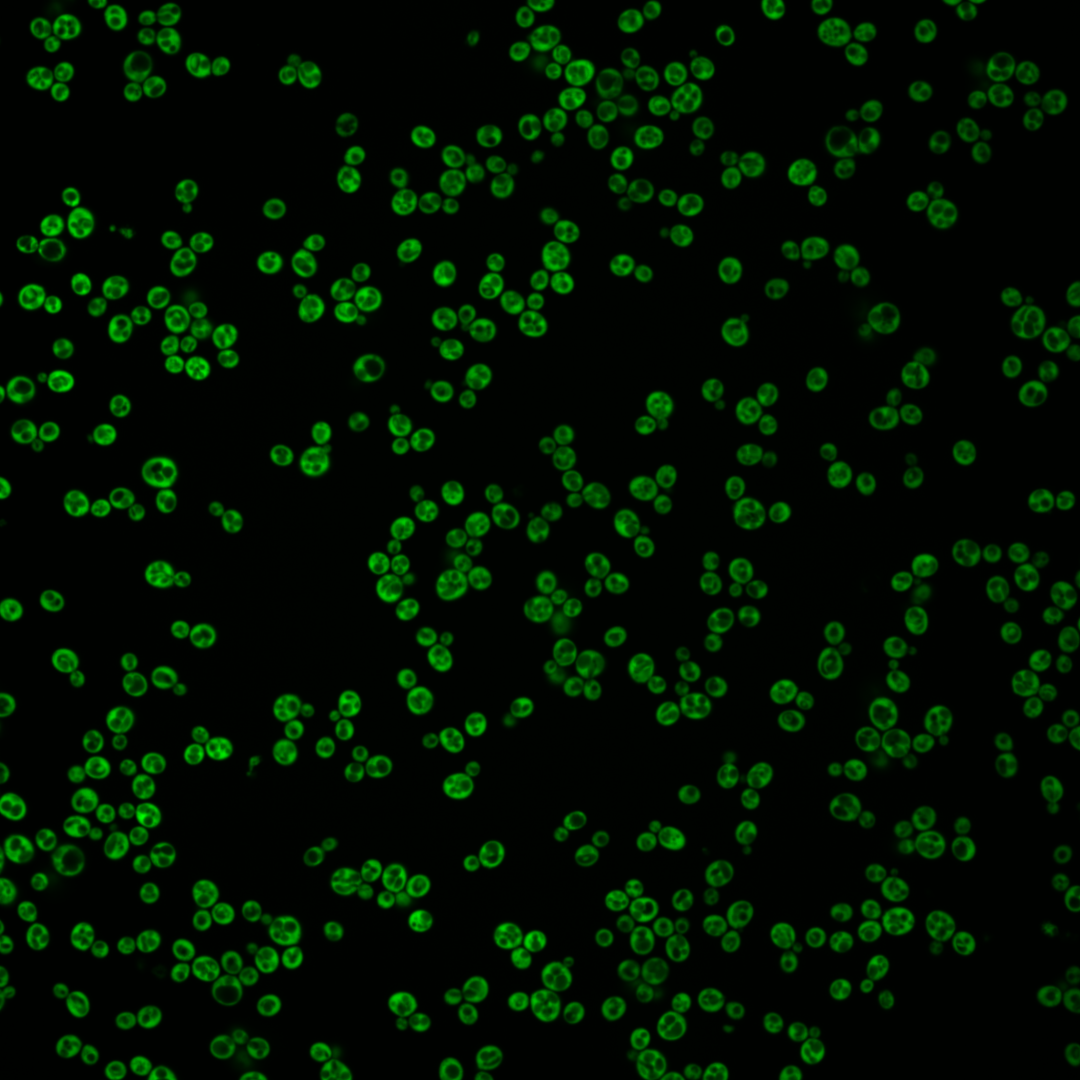
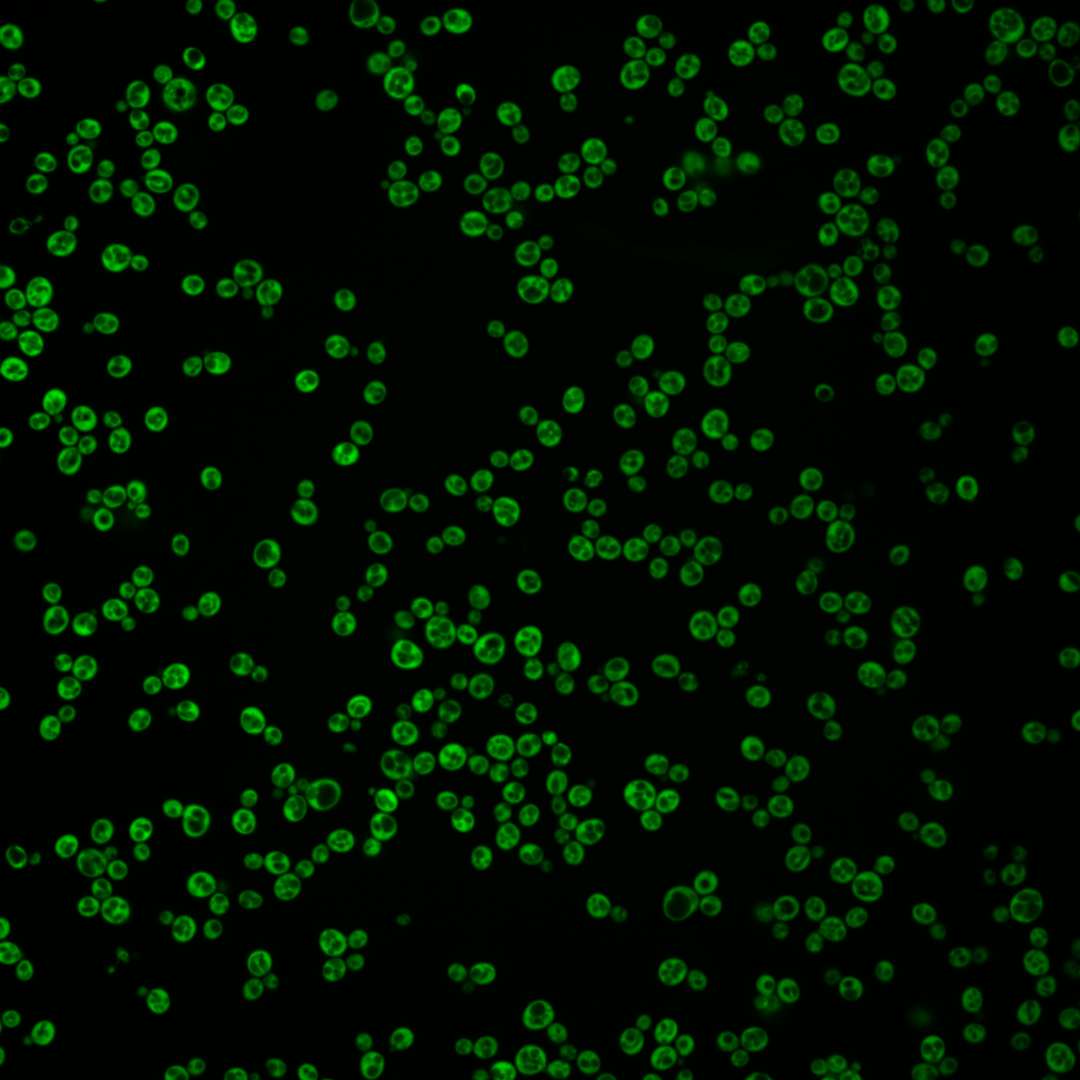

| Standard name | |
|---|---|
| Human Ortholog | |
| Description | Ribosomal 60S subunit protein L41A; comprises only 25 amino acids; rpl41a rpl41b double null mutant is viable; homologous to mammalian ribosomal protein L41, no bacterial homolog; RPL41A has a paralog, RPL41B, that arose from the whole genome duplication |
Micrographs




















































































Sub-cellular Localization
Yeast GFP Assignment
Protein Abundance
Localization Change
External localization resources
| ensLOC | DeepLoc | |||||||||||||||||||||||
|---|---|---|---|---|---|---|---|---|---|---|---|---|---|---|---|---|---|---|---|---|---|---|---|---|
| Localization | WT1 | WT2 | WT3 | RAP60 | RAP140 | RAP220 | RAP300 | RAP380 | RAP460 | RAP540 | RAP620 | RAP700 | HU80 | HU120 | HU160 | rpd3Δ_1 | rpd3Δ_2 | rpd3Δ_3 | WT1 | WT2 | WT3 | AF100 | AF140 | AF180 |
| Cortical Patches | 0 | 0 | 0 | 0 | 0 | 1 | – | 3 | 4 | 8 | 11 | 16 | 0 | 0 | 0 | 0 | 0 | 0 | 0 | 0 | 0 | 0 | 0 | 0 |
| Bud | 1 | 0 | 2 | 1 | 1 | 1 | – | 1 | 2 | 0 | 4 | 2 | 3 | 4 | 3 | 0 | 0 | 0 | 0 | 1 | 0 | 0 | 3 | 8 |
| Bud Neck | 0 | 0 | 0 | 0 | 0 | 0 | – | 0 | 0 | 0 | 0 | 0 | 0 | 0 | 0 | 0 | 0 | 0 | 0 | 0 | 0 | 0 | 0 | 0 |
| Bud Site | 0 | 0 | 0 | 0 | 0 | 0 | – | 0 | 0 | 0 | 0 | 0 | 0 | 0 | 0 | 0 | 0 | 0 | – | – | – | – | – | – |
| Cell Periphery | 0 | 0 | 0 | 1 | 7 | 14 | – | 12 | 14 | 21 | 19 | 20 | 2 | 3 | 6 | 3 | 0 | 1 | 0 | 0 | 0 | 0 | 0 | 0 |
| Cytoplasm | 316 | 137 | 130 | 217 | 284 | 307 | – | 364 | 276 | 270 | 245 | 272 | 472 | 806 | 825 | 218 | 353 | 336 | 303 | 129 | 117 | 114 | 403 | 574 |
| Endoplasmic Reticulum | 0 | 0 | 0 | 0 | 2 | 20 | – | 90 | 44 | 54 | 42 | 52 | 2 | 5 | 9 | 13 | 18 | 26 | 0 | 1 | 0 | 0 | 1 | 2 |
| Endosome | 0 | 1 | 0 | 0 | 0 | 0 | – | 0 | 0 | 0 | 0 | 0 | 0 | 0 | 0 | 0 | 0 | 0 | 0 | 0 | 0 | 0 | 0 | 0 |
| Golgi | 0 | 0 | 0 | 0 | 1 | 0 | – | 1 | 3 | 5 | 5 | 9 | 1 | 0 | 0 | 0 | 1 | 2 | 0 | 0 | 0 | 0 | 0 | 0 |
| Mitochondria | 0 | 0 | 0 | 0 | 1 | 0 | – | 1 | 5 | 3 | 11 | 21 | 0 | 0 | 0 | 0 | 2 | 6 | 0 | 0 | 1 | 0 | 0 | 0 |
| Nucleus | 0 | 0 | 0 | 0 | 0 | 0 | – | 0 | 0 | 1 | 0 | 0 | 0 | 0 | 0 | 0 | 0 | 0 | 0 | 1 | 0 | 1 | 1 | 0 |
| Nuclear Periphery | 0 | 0 | 0 | 0 | 0 | 0 | – | 0 | 0 | 0 | 0 | 0 | 0 | 0 | 0 | 0 | 0 | 0 | 0 | 0 | 0 | 0 | 0 | 0 |
| Nucleolus | 0 | 0 | 0 | 0 | 0 | 0 | – | 1 | 0 | 0 | 0 | 3 | 1 | 0 | 1 | 2 | 0 | 0 | 0 | 0 | 0 | 0 | 0 | 0 |
| Peroxisomes | 0 | 0 | 0 | 0 | 0 | 0 | – | 0 | 0 | 0 | 0 | 0 | 0 | 0 | 0 | 0 | 0 | 0 | 0 | 0 | 0 | 0 | 0 | 0 |
| SpindlePole | 0 | 0 | 0 | 0 | 0 | 0 | – | 0 | 0 | 0 | 0 | 0 | 0 | 0 | 0 | 0 | 0 | 0 | 0 | 0 | 0 | 0 | 0 | 0 |
| Vac/Vac Membrane | 1 | 0 | 0 | 0 | 0 | 0 | – | 1 | 0 | 0 | 0 | 0 | 0 | 1 | 0 | 1 | 2 | 1 | 2 | 2 | 2 | 4 | 7 | 5 |
| Unique Cell Count | 318 | 138 | 130 | 217 | 290 | 333 | 466 | 334 | 345 | 314 | 368 | 475 | 814 | 834 | 221 | 356 | 342 | 311 | 141 | 122 | 125 | 425 | 601 | |
| Labelled Cell Count | 318 | 138 | 132 | 219 | 296 | 343 | 474 | 348 | 362 | 337 | 395 | 481 | 819 | 844 | 237 | 376 | 372 | 311 | 141 | 122 | 125 | 425 | 601 | |
Yeast GFP Assignment
Protein Abundance
| Screen | WT1 | WT2 | WT3 | RAP60 | RAP140 | RAP220 | RAP300 | RAP380 | RAP460 | RAP540 | RAP620 | RAP700 | HU80 | HU120 | HU160 | rpd3Δ_1 | rpd3Δ_2 | rpd3Δ_3 | AF100 | AF140 | AF180 |
|---|---|---|---|---|---|---|---|---|---|---|---|---|---|---|---|---|---|---|---|---|---|
| Mean Cell GFP Intensity (1e-4) | 196.0 | 241.8 | 108.9 | 156.9 | 128.2 | 98.6 | – | 73.4 | 64.5 | 59.2 | 54.3 | 49.8 | 205.8 | 207.6 | 186.2 | 262.7 | 240.1 | 250.3 | 187.4 | 211.2 | 225.8 |
| Std Deviation (1e-4) | 42.1 | 52.4 | 25.5 | 32.3 | 32.1 | 22.7 | – | 17.9 | 15.9 | 13.0 | 12.7 | 12.5 | 50.7 | 46.1 | 43.1 | 86.9 | 91.2 | 82.2 | 47.1 | 59.3 | 63.9 |
| Intensity Change (Log2) | – | – | – | 0.53 | 0.24 | -0.14 | – | -0.57 | -0.75 | -0.88 | -1.0 | -1.13 | 0.92 | 0.93 | 0.77 | 1.27 | 1.14 | 1.2 | 0.78 | 0.96 | 1.05 |
Localization Change
| Localization | RAP60 | RAP140 | RAP220 | RAP300 | RAP380 | RAP460 | RAP540 | RAP620 | RAP700 | HU80 | HU120 | HU160 | rpd3Δ_1 | rpd3Δ_2 | rpd3Δ_3 |
|---|---|---|---|---|---|---|---|---|---|---|---|---|---|---|---|
| Cortical Patches | 0 | 0 | 0 | – | 0 | 0 | 0 | 0 | 0 | 0 | 0 | 0 | 0 | 0 | 0 |
| Bud | 0 | 0 | 0 | – | 0 | 0 | 0 | 0 | 0 | 0 | 0 | 0 | 0 | 0 | 0 |
| Bud Neck | 0 | 0 | 0 | – | 0 | 0 | 0 | 0 | 0 | 0 | 0 | 0 | 0 | 0 | 0 |
| Bud Site | 0 | 0 | 0 | – | 0 | 0 | 0 | 0 | 0 | 0 | 0 | 0 | 0 | 0 | 0 |
| Cell Periphery | 0 | 0 | 0 | – | 0 | 0 | 2.9 | 2.9 | 2.7 | 0 | 0 | 0 | 0 | 0 | 0 |
| Cytoplasm | 0 | -1.7 | -3.3 | – | -5.9 | -5.1 | -5.8 | -5.8 | -6.5 | -0.9 | -1.1 | -1.2 | -1.3 | -1.0 | -1.5 |
| Endoplasmic Reticulum | 0 | 0 | 2.9 | – | 5.4 | 4.3 | 4.8 | 4.4 | 4.5 | 0 | 0 | 0 | 0 | 0 | 3.2 |
| Endosome | 0 | 0 | 0 | – | 0 | 0 | 0 | 0 | 0 | 0 | 0 | 0 | 0 | 0 | 0 |
| Golgi | 0 | 0 | 0 | – | 0 | 0 | 0 | 0 | 0 | 0 | 0 | 0 | 0 | 0 | 0 |
| Mitochondria | 0 | 0 | 0 | – | 0 | 0 | 0 | 0 | 2.8 | 0 | 0 | 0 | 0 | 0 | 0 |
| Nucleus | 0 | 0 | 0 | – | 0 | 0 | 0 | 0 | 0 | 0 | 0 | 0 | 0 | 0 | 0 |
| Nuclear Periphery | 0 | 0 | 0 | – | 0 | 0 | 0 | 0 | 0 | 0 | 0 | 0 | 0 | 0 | 0 |
| Nucleolus | 0 | 0 | 0 | – | 0 | 0 | 0 | 0 | 0 | 0 | 0 | 0 | 0 | 0 | 0 |
| Peroxisomes | 0 | 0 | 0 | – | 0 | 0 | 0 | 0 | 0 | 0 | 0 | 0 | 0 | 0 | 0 |
| SpindlePole | 0 | 0 | 0 | – | 0 | 0 | 0 | 0 | 0 | 0 | 0 | 0 | 0 | 0 | 0 |
| Vacuole | 0 | 0 | 0 | – | 0 | 0 | 0 | 0 | 0 | 0 | 0 | 0 | 0 | 0 | 0 |
External localization resources
Images






























Protein Concentration and Protein Localization Data
| R1 | R2 | R3 | ||||||||||||||||
|---|---|---|---|---|---|---|---|---|---|---|---|---|---|---|---|---|---|---|
| G1 Pre-START | G1 Post-START | S/G2 | Metaphase | Anaphase | Telophase | G1 Pre-START | G1 Post-START | S/G2 | Metaphase | Anaphase | Telophase | G1 Pre-START | G1 Post-START | S/G2 | Metaphase | Anaphase | Telophase | |
| Concentration | 160.8752 | 285.6369 | 222.2298 | 172.1388 | 211.4679 | 233.9378 | 192.9565 | 277.8344 | 233.928 | 212.5582 | 229.0459 | 190.0723 | 210.1999 | 285.7337 | 289.8093 | 257.5035 | 280.1833 | 211.3374 |
| Actin | 0.0103 | 0.0004 | 0.002 | 0.0014 | 0.0054 | 0.0077 | 0.022 | 0.0003 | 0.0018 | 0.0077 | 0.0017 | 0.0021 | 0.0301 | 0.0023 | 0.0008 | 0.0013 | 0.0006 | 0.0034 |
| Bud | 0.0076 | 0.001 | 0.0025 | 0.0041 | 0.0077 | 0.0048 | 0.0037 | 0.0007 | 0.0036 | 0.003 | 0.0026 | 0.0011 | 0.0042 | 0.002 | 0.0033 | 0.007 | 0.0014 | 0.0026 |
| Bud Neck | 0.0027 | 0.0009 | 0.0014 | 0.0014 | 0.002 | 0.0045 | 0.0016 | 0.0009 | 0.0013 | 0.0018 | 0.0014 | 0.0032 | 0.0014 | 0.0006 | 0.0014 | 0.0014 | 0.0006 | 0.0011 |
| Bud Periphery | 0.0078 | 0.0006 | 0.0019 | 0.0052 | 0.0063 | 0.0069 | 0.0057 | 0.0004 | 0.0043 | 0.0013 | 0.0013 | 0.0019 | 0.0033 | 0.0007 | 0.0056 | 0.0051 | 0.0002 | 0.0007 |
| Bud Site | 0.0047 | 0.0013 | 0.0023 | 0.0023 | 0.0055 | 0.0012 | 0.0045 | 0.0011 | 0.0025 | 0.0015 | 0.0008 | 0.0009 | 0.0083 | 0.0108 | 0.0009 | 0.0016 | 0.0001 | 0.0004 |
| Cell Periphery | 0.0735 | 0.0574 | 0.0545 | 0.0537 | 0.0332 | 0.02 | 0.0806 | 0.0469 | 0.0347 | 0.0558 | 0.0107 | 0.0411 | 0.0291 | 0.0321 | 0.0197 | 0.0352 | 0.0016 | 0.0029 |
| Cytoplasm | 0.4047 | 0.7947 | 0.5962 | 0.3124 | 0.5705 | 0.6266 | 0.4856 | 0.8529 | 0.7733 | 0.3928 | 0.7181 | 0.5178 | 0.5453 | 0.8545 | 0.8254 | 0.5401 | 0.9115 | 0.5954 |
| Cytoplasmic Foci | 0.0291 | 0.0005 | 0.0224 | 0.0364 | 0.021 | 0.0117 | 0.0141 | 0.0005 | 0.0026 | 0.0034 | 0.0205 | 0.0065 | 0.0174 | 0.0021 | 0.0012 | 0.0048 | 0.0015 | 0.0415 |
| Eisosomes | 0.0017 | 0 | 0.0007 | 0.0022 | 0.0025 | 0.0001 | 0.0012 | 0.0001 | 0.001 | 0 | 0.0012 | 0.0004 | 0.0027 | 0.0001 | 0.0001 | 0.0004 | 0 | 0.0005 |
| Endoplasmic Reticulum | 0.0316 | 0.0041 | 0.0097 | 0.0057 | 0.0038 | 0.0175 | 0.0171 | 0.0028 | 0.0024 | 0.0027 | 0.0054 | 0.042 | 0.0169 | 0.0012 | 0.0018 | 0.0016 | 0.0003 | 0.004 |
| Endosome | 0.0185 | 0.0007 | 0.0097 | 0.0557 | 0.0127 | 0.0306 | 0.008 | 0.0004 | 0.0016 | 0.004 | 0.0056 | 0.0053 | 0.0125 | 0.0007 | 0.0014 | 0.0026 | 0.0008 | 0.0433 |
| Golgi | 0.0029 | 0.0001 | 0.0028 | 0.0038 | 0.0019 | 0.0053 | 0.0026 | 0.0001 | 0.0003 | 0.0004 | 0.0009 | 0.001 | 0.0034 | 0.0003 | 0.0002 | 0.0003 | 0.0001 | 0.0044 |
| Lipid Particles | 0.0102 | 0.0014 | 0.0054 | 0.0117 | 0.013 | 0.0085 | 0.0068 | 0.0011 | 0.0035 | 0.0038 | 0.0057 | 0.004 | 0.0081 | 0.0012 | 0.0007 | 0.0016 | 0.0003 | 0.0352 |
| Mitochondria | 0.0248 | 0.0009 | 0.0172 | 0.0203 | 0.0198 | 0.0149 | 0.0207 | 0.0009 | 0.0115 | 0.0011 | 0.0126 | 0.0168 | 0.0291 | 0.0029 | 0.0128 | 0.0193 | 0.0021 | 0.0161 |
| None | 0.0219 | 0.0006 | 0.013 | 0.0281 | 0.0081 | 0.0018 | 0.0109 | 0.001 | 0.0039 | 0.0007 | 0.0132 | 0.0284 | 0.0199 | 0.0015 | 0.0014 | 0.0181 | 0.0015 | 0.0113 |
| Nuclear Periphery | 0.0677 | 0.0102 | 0.0197 | 0.0224 | 0.0158 | 0.0339 | 0.1039 | 0.0101 | 0.0161 | 0.0408 | 0.0288 | 0.0743 | 0.064 | 0.0069 | 0.0109 | 0.016 | 0.0141 | 0.0598 |
| Nucleolus | 0.0321 | 0.002 | 0.0167 | 0.0382 | 0.0116 | 0.0031 | 0.0094 | 0.0025 | 0.0212 | 0.0068 | 0.0253 | 0.0463 | 0.0189 | 0.0029 | 0.0019 | 0.0116 | 0.0054 | 0.0891 |
| Nucleus | 0.0357 | 0.0102 | 0.0203 | 0.0223 | 0.0209 | 0.0307 | 0.0529 | 0.0125 | 0.0225 | 0.0281 | 0.0442 | 0.0967 | 0.0656 | 0.0122 | 0.0136 | 0.0393 | 0.0295 | 0.0458 |
| Peroxisomes | 0.0014 | 0.0001 | 0.0011 | 0.0015 | 0.0035 | 0.0037 | 0.0011 | 0.0001 | 0.0005 | 0.0003 | 0.001 | 0.0003 | 0.0014 | 0.0002 | 0.0002 | 0.0006 | 0.0001 | 0.002 |
| Punctate Nuclear | 0.0019 | 0.0001 | 0.0011 | 0.0013 | 0.0009 | 0.0036 | 0.0073 | 0.0001 | 0.0004 | 0.0004 | 0.0025 | 0.0044 | 0.0031 | 0.0001 | 0.0001 | 0.0002 | 0.0003 | 0.0109 |
| Vacuole | 0.1734 | 0.1047 | 0.1649 | 0.2587 | 0.1848 | 0.1094 | 0.1116 | 0.0596 | 0.0738 | 0.3227 | 0.0673 | 0.0768 | 0.0842 | 0.0572 | 0.0793 | 0.2096 | 0.0137 | 0.0152 |
| Vacuole Periphery | 0.0358 | 0.0081 | 0.0345 | 0.1114 | 0.0488 | 0.0534 | 0.0287 | 0.0049 | 0.0173 | 0.1208 | 0.0294 | 0.0285 | 0.0312 | 0.0076 | 0.0173 | 0.0821 | 0.0142 | 0.0144 |
Sequencing Data
| R1 | R2 | |||||||||
|---|---|---|---|---|---|---|---|---|---|---|
| G1 Post-START | S/G2 | Metaphase | Anaphase | Telophase | G1 Post-START | S/G2 | Metaphase | Anaphase | Telophase | |
| Gene Expression | 8275.5333 | 10205.1996 | 14995.2567 | 7777.3471 | 14333.6327 | 14619.0843 | 8934.3602 | 10247.9185 | 14689.8232 | 7075.598 |
| Translational Efficiency | 2.5456 | 2.2162 | 1.3227 | 3.7872 | 1.581 | 1.2385 | 1.9004 | 2.0393 | 1.2259 | 2.1895 |
Hit Data
| Dataset | Hit |
|---|---|
| Protein Concentration | ✘ |
| Protein Localization | ✘ |
| Gene Expression | ✘ |
| Translational Efficiency | ✘ |
Endocytosis
| Temp | Actin Patch (Sac6-tdTomato) | Cortical Patch (Sla1-GFP) | Late Endosome (Snf7-GFP) | Vacuole (Vph1-GFP) |
|---|---|---|---|---|
| 37℃ | ||||
| RT |
Cell Cycle Omics
CYCLoPs (Rpl41a-GFP)
| Gene / Allele | Actin Patch (Sac6-tdTomato) | Cortical Patch (Sla1-GFP) | Late Endosome (Snf7-GFP) | Vacuole (Sac6-tdTomato) |
|---|
| Gene | Images |
|---|
| Gene | Images |
|---|
Images are not yet available
Images are not yet available